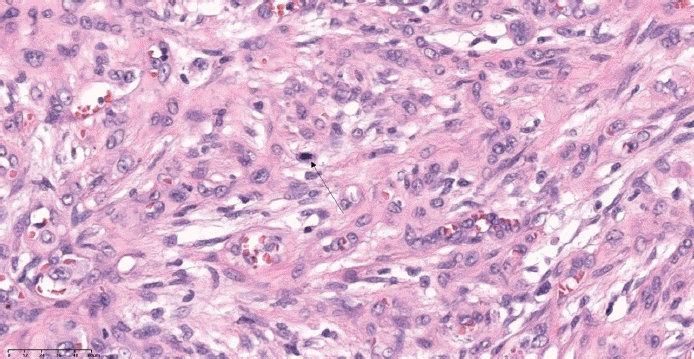
Fig. 6.

Epithelioid Hemangioendothelioma Arising From the Upper Mediastinum
상부 종격동에 발생한 상피모양 혈관내피종
Article information
Abstract
Epithelioid hemangioendothelioma is classified by WHO as a malignancy that presents various clinical behaviors in a range of low and high grades. This rare cancer typically arises from the lung, liver, and other organs. A domestic literature review revealed only two cases originating from the external auditory canal and nasal cavity. A 68-year old female visited the hospital for an incidentally detected 3.5 cm mass in the left upper mediastinum between the common carotid and subclavian artery. An open biopsy under general anesthesia revealed the malignancy of epithelioid hemangioendothelioma. The patient underwent complete excision of the mass via transcervical approach and adjunctive radiation therapy thereafter. The patient has been followed up 2 years without any evidence of recurrence.
Introduction
Epithelioid hemangioendothelioma is a tumor that arises primarily from the vasculature of the lung, liver, or other organs [1]. According to the World Health Organization, it is classified as a malignant tumor [2]. Its clinical presentation is heterogeneous, and its malignant potential falls along an intermediate spectrum between low and high grades [3,4]. In Korea, only one case involving the external auditory canal has been reported [5], and only one case involving the nasal cavity has been reported [6], indicating that this disease remains very rare in Korea. Complete surgical resection is recommended for all cases of epithelioid hemangioendothelioma, and additional therapy is required in high-risk patients. However, chemoradiotherapy to date has been reported to not substantially improve survival [7].
Here, we report a case of epithelioid hemangioendothelioma arising in the upper mediastinum between the subclavian artery and the common carotid artery that was treated via a cervical approach, together with a review of the literature.
Case
This study was approved by the Institutional Review Board of Chonnam National University Hwasun Hospital (CNUHH-2025-061).
A 68-year-old female presented after an incidental upper mediastinal mass was detected. She had undergone surgical clipping for subarachnoid hemorrhage due to rupture of an anterior communicating artery aneurysm 16 years earlier, and the mass was identified on periodic imaging performed as part of follow-up for that condition. Apart from a history of hypertension, there were no other notable medical issues.
On neck computed tomography, an approximately 3.5 cm, oval to round mass with heterogeneous contrast enhancement was observed in the left upper mediastinum (Fig. 1). The lesion widened the interval between the common carotid artery, internal jugular vein, and subclavian artery and appeared adherent to the common carotid and subclavian arteries. Opacification obstructing the left maxillary sinus and both anterior ethmoid sinuses was also noted, raising suspicion of sinusitis. On upper airway endoscopy, there were no remarkable findings in the larynx or upper trachea, vocal cord mobility was good bilaterally, bilateral nasal polyps were observed, and mucopurulent discharge was present in the left middle meatus.

Neck CT demonstrates a 3.5 cm sized somewhat elliptical somewhat round heterogeneously enhanced mass in the left upper mediastinum between the space of common carotid artery (short arrow), internal jugular vein (long arrow), and subclavian artery (middle sized arrow), adhered into the common carotid and subclavian artery.
A core needle biopsy performed at another hospital revealed atypical cells, and an inflammatory lesion, metastatic carcinoma of epithelial origin, or sarcoma was suspected. Because the biopsy results were inconclusive between inflammation and carcinoma and a repeat core needle biopsy at our institution was expected to yield similar findings, we first performed an incisional biopsy of the mass and left endoscopic sinus surgery under general anesthesia.
Intraoperatively, a firm, round, white mass with a fibrous capsule, measuring approximately 4 cm and relatively well demarcated, was identified in the deep carotid space inferior to the left common carotid artery and jugular vein (Fig. 2). It was located immediately lateral to the thyroid gland and was not associated with the vagus nerve. White necrotic tissue was seen within the mass, but the appearance was not consistent with that of a neurogenic tumor. Frozen-section analysis suggested sarcoma or poorly differentiated carcinoma. However, we did not proceed directly to definitive surgery based on this finding. The operation was concluded with a plan to determine subsequent management according to the final histopathology. This decision was informed by our clinical experience that frozen-section and final histopathologic diagnoses can differ, and by the consideration that, if the final diagnosis were not malignant, surgery entailing unnecessary complications could be avoided.

Intraoperative finding for incisional biopsy demonstrates about 4 cm sized well-demarcated firm round mass with whitish fibrous capsule (long arrow) under the common carotid artery (short arrow).
The sinus surgery confirmed fungal maxillary sinusitis. The final result of the incisional biopsy of the upper mediastinal mass was epithelioid hemangioendothelioma, and it was diagnosed as a malignant tumor. In a myxohyaline stroma, elongated cord-like arrangements of endothelial cells were embedded. The tumor cells had eosinophilic cytoplasm and vesicular, round or oval nuclei, and cytoplasmic vacuolization was observed in multiple cells (Fig. 3). On immunohistochemistry, the tumor cells were positive for CD34, an endothelial marker, and positive for ERG (E26 transformation specific [ETS]-related gene), a vascular marker (Fig. 4).

Pathologic findings of the incised mass demonstrates as follows: cords and strands of endothelial cells are embedded in a myxohyaline stroma (A, H&E stain, ×100); tumor cells have vesicular, round to oval nuclei with eosinophilic cytoplasm. Cytoplasmic vacuolization can be seen in several cells (B, H&E stain, ×400). H&E, hematoxylin-eosin.

Immunohistochemical staining demonstrates diffuse positive for ETS(E26 transformation specific)-related gene (ERG), a vascular marker (ERG stain, ×100).
After the mediastinal mass was ultimately judged to be malignant and considered a tumor for which surgical resection should take priority, we planned complete excision under general anesthesia. Anticipating a risk of injury to major vessels and the need for a wider operative field, we proceeded via a cervical approach with a thoracic surgeon available. Owing to the prior incisional biopsy and the malignant nature of the lesion, there were substantial adhesions around the mass. The mass was firm, well consolidated, involving the left upper mediastinum and the paraesophageal space. It was located inferior to the common carotid artery, medial to the jugular vein and vagus nerve, and lateral to the tracheoesophageal groove and recurrent laryngeal nerve. It was connected to branches of the subclavian artery and vein, including the thyrocervical trunk, and was also connected to the thoracic duct. We achieved complete resection by carefully dissecting the surrounding tissues while establishing a safe dissection plane (Fig. 5A). Although the mass was adherent to the subclavian and internal jugular veins, there was no direct invasion, and complete separation was possible, so venous ligation was not performed. Histopathology of the completely resected mass also confirmed epithelioid hemangioendothelioma (Fig. 5B).

Completely-excised specimen demonstrates a 3.5 cm sized somewhat round bumpy dark reddish to light brownish colored solid mass with multiple visible hemorrhagic spots on the surface grossly (A), and the tumor is comprised of cords and nests of atypical endothelial cells with numerous small vascular lumina containing erythrocytes microscopically (B, hematoxylin-eosin stain, ×200).
Deyrup, et al. [3] classified epithelioid hemangioendothelioma based on tumor size and the number of mitotic figures. They reported that patients are at high risk when the tumor size exceeds 3 cm and there are at least 3 mitotic figures per 50 high-power fields, because survival is significantly reduced under these criteria. In the present case, 3 mitotic figures per 50 high-power fields were observed (Fig. 6). According to these criteria, the patient was classified as high risk, and additional treatment was determined through multidisciplinary care. Because no chemotherapeutic agent with established efficacy was available, radiotherapy alone was administered at 5440 cGy. The patient is currently being followed for 2 years without recurrence.
Discussion
Epithelioid hemangioendothelioma is a rare tumor that originates from vascular endothelial cells. It has previously been referred to as a simple hemangioendothelioma, histiocytic hemangioma, or a vascular tumor. When epithelioid hemangioendothelioma was first described in 1989, its clinical behavior was regarded as neither entirely benign nor fully malignant. The term “hemangioendothelioma” itself has historically reflected the perception that these tumors show intermediate clinical behavior [1]. However, in the most recent World Health Organization classification, epithelioid hemangioendothelioma is described not as an intermediate-grade sarcoma but as a fully malignant vascular tumor [2]. This classification reflects the observation that 15% of patients experience progression leading to death [1,3,4]. Nonetheless, the disease continues to be recognized as exhibiting a wide spectrum of clinical behavior between hemangioendothelioma and angiosarcoma [2,3].
Epithelioid hemangioendothelioma can occur at any age with a similar incidence in male and female, is most often solitary, and may be accompanied by pain [5]. Histologically, ovoid or polygonal epithelioid cells contain abundant eosinophilic cytoplasm, with round nuclei, and relatively little nuclear pleomorphism or mitotic activity [5]. On immunohistochemistry, variable positivity is observed for endothelial markers including CD31, CD34, and factor VIII-related antigen. The key histologic differential diagnoses include metastatic adenocarcinoma, chondromyxoid sarcoma, epithelioid sarcoma, and epithelioid angiosarcoma [4].
In recent years, efforts have been made to stratify patients who require aggressive treatment versus those who do not, with the aim of improving disease-specific survival. In a large-cohort study, tumor size and mitotic count were evaluated as prognostic factors [3,8]. Specifically, high-risk patients defined by a tumor size greater than 3 cm and at least 3 mitotic figures per 50 high-power fields showed higher metastasis rates than low-risk patients, at 25% vs. 15%, respectively. The 5-year survival rates also differed significantly, at 59% vs. 100%, respectively [3]. In the present case, the tumor measured 3.5 cm and the mitotic count was 3, leading to classification as high risk, and radiotherapy was administered after aggressive surgical resection.
Although complete surgical resection and additional aggressive therapy are considered essential for all high-risk epithelioid hemangioendothelioma, currently available adjuvant treatments, including chemotherapy and radiotherapy, have been reported not to significantly improve survival. Chemotherapy regimens using mitomycin C, cyclophosphamide, vincristine, cisplatin, 5-fluorouracil, gemcitabine, docetaxel, and etoposide have been reported to show limited benefit [1,9]. Encouragingly, therapies targeting vascular endothelial growth factor (VEGF) have attracted attention as a notable approach. Antiangiogenic therapy with bevacizumab administered over several years has been investigated across multiple clinical settings, including phase 2 trials [10-12]. Belmont, et al. [11] reported a favorable partial response in a patient with pulmonary epithelioid hemangioendothelioma treated with bevacizumab in combination with carboplatin and paclitaxel. Trautmann, et al. [12] also reported successful treatment using bevacizumab in locally recurrent epithelioid hemangioendothelioma. In our institution, however, multidisciplinary discussion led the medical oncology team to decide against VEGF-targeted therapy in this case.
If an upper mediastinal mass widens the interval between major vessels and appears adherent to them, the possibility of epithelioid hemangioendothelioma should be considered.
Supplementary Materials
Korean translation of this article is available with the Online-only Data Supplement athttps://doi.org/10.3342/kjorl-hns.2025.00171.
Notes
Acknowledgments
None
Author Contribution
Conceptualization: Joo Yeon Koo, Joon Kyoo Lee. Data curation: all authors. Formal analysis: Joo Yeon Koo, Joon Kyoo Lee. Investigation: Joon Kyoo Lee. Methodology: Joo Yeon Koo, Joon Kyoo Lee. Project administration: Joon Kyoo Lee. Resources: all authors. Software: Juwon Hwang, Joo Yeon Koo, Joon Kyoo Lee. Supervision: Joon Kyoo Lee. Validation: Joo Yeon Koo, Joon Kyoo Lee. Visualization: Joon Kyoo Lee. Writing—original draft: Gun Ju Kim, Joon Kyoo Lee. Writing—review & editing: Joon Kyoo Lee.